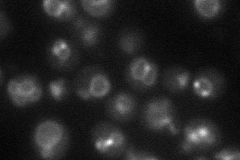
YDL077C
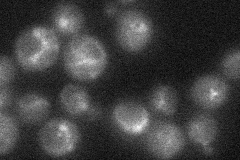
YDL077C
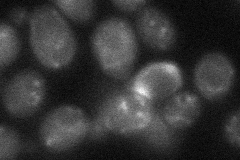
YDL077C
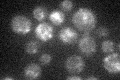
YDL077C

View description
Vacuolar protein that plays a critical role in the tethering steps of vacuolar membrane fusion by facilitating guanine nucleotide exchange on small guanosine triphosphatase Ypt7p
Localization:
Intensity:
Fold change:
Significance:
-
C’ GFP library in SD

vacuole19.48 -
N' NOP1pr-GFP in SD

vacuole membrane68.5273 -
N' TEF2pr-mCherry in SD
vacuole membrane41.2313 -
N' NATIVEpr-GFP in SD
vacuole membrane21.9348 -
N' TEF2pr-VC and Cyto-VN in SD
punctate33.2577 -
C’ GFP library in SD+DTT

vacuole24.771.27No -
C’ GFP library in SD+H2O2

vacuole22.491.15No -
C’ GFP library in Starvation Media
vacuole22.181.13No -
C’ GFP library on the background of Pup2-DaMP

vacuole -
C’ GFP library on the background of CCT mutant

vacuole16.21280.83184No
